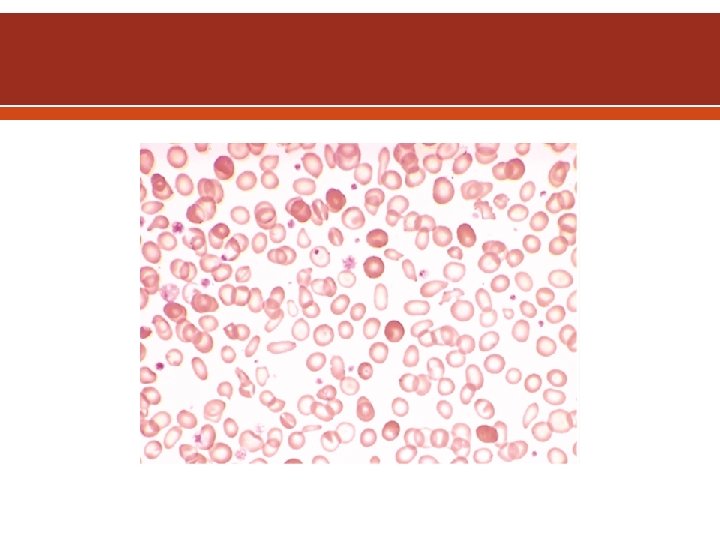
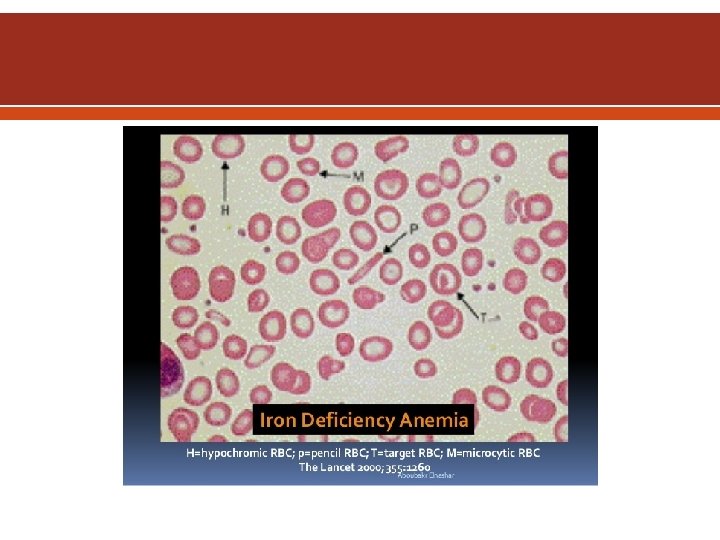

Iron Deficiency Anemia IDA Ass prof Abeer Anwer

Iron Deficiency Anemia (IDA) Ass. prof. Abeer Anwer

Objectives Explain background, definition, epidemiology, and etiology of iron deficiency anemia (IDA) Outline diagnostic algorithm of IDA Identify key laboratory findings to diagnose IDA

Background Anemia is a group of disease characterized by a decrease in either hemoglobin (Hb) or circulating red blood cells (RBCs) o Results in reduced oxygen-carrying capacity of the blood According to World Health Organization (WHO) o 1. 6 billion people (1/4 of world’s population ) are anemic Not an innocent bystander; affects both length and quality of life (QOL) IDA occurs across all populations and is associated with o Diminished QOL o Physical and cognitive performance, and o Unfavorable clinical outcomes

Morphological Classification Anemia Macrocytic Megaloblastic 1. 2. Vitamin B 12 deficiency Folic acid deficiency Normocytic Non-megaloblastic 1. 2. 3. 4. Hepatic disease Drug-induced anemia Hypothyroidism Reticulocytosis 1. 2. 3. 4. Microcytic Genetic Anomaly IDA Recent blood loss Hemolysis Bone marrow failure Anemia of chronic disease 1. 2. Sickle cell Thalassemia

Definition According to WHO o Anemia is defined as Hb <130 g/L in men or <120 g/L in female IDA is the result of long-term negative iron balances o Progressive loss of iron stores in the form of hemosiderin and ferritin IDA is defined as o Anemia with biochemical evidence of iron deficiency based on following laboratory findings • Serum ferritin, total iron binding capacity (TIBC), transferrin saturation, or transferrin receptor

Epidemiology IDA is the most common nutritional deficiency in developing and developed countries IDA is considered to be the leading cause of anemia worldwide, accounting for as many as 50% of cases Prevalence of IDA greatly varies according to age, gender, physiological, pathological, environmental, and socioeconomic conditions prevalence of IDA o Young children 1. 2% o Women of childbearing age 4. 5%

Process of RBC Production & Maturation RBC production Iron + Hb

Iron Metabolism: Figure 16 -8: Iron metabolism

Recent in iron metabolism the TMPRSS 6 gene encoding Matriptase-2 (MT-2). . is a transmembrane serine protease that cleaves Hemojuvelin, a major regulator of hepcidin expression and plays an essential role in down-regulating hepcidin, the key regulator of iron homeostasis. When blood iron levels are low, this signaling pathway reduces hepcidin production, allowing more iron from the diet to be absorbed through the intestines and transported out of storage sites (particularly in the liver and spleen) into the bloodstream

Erythropoietin is the specific erythroid growth factor. It is produced in the kidneys by peritubular interstitial cells in response to hypoxia. It acts on erythropoietin receptors on the surface of developing erythroid cells. The expression of this receptor declines rapidly with maturation of the cells. Hemoglobin consists of four hem & four globin chains. The hem consists of a protoporphyrin ring with ferrous iron in the center. The globin chains consist of 2 α & 2 non α chains. The main hemoglobin in post natal life is Hb. A (α 2β 2). Also present in adults Hb. A 2 (α 2δ 2) up to 3. 5% & Hb. F (α 2γ 2) up to 1%.


Iron transport: two atoms of ferric iron can attach to a single molecule of transferrin which is synthesized by the liver. Normally transferrin is one third saturated & it gains most of the iron from the macrophages of the RE system which degrade hemoglobin after death of old red cells (not from the GIT). The developing erythroblasts are rich in transferrin receptors so they get most of transferrin iron. Storage iron: ferritin is water soluble iron storage protein. It is synthesized by the liver. One molecule can bind 4000 iron atoms. Hemosiderin is water insoluble & is formed by partial degradation of ferritin. It is visible in the macrophages by Prussian blue stain (iron stain)

Iron Balance Normal iron content of the body o 3 -4 g (Hb, myoglobin, and cytochromes) Iron is best absorb as ferrous (Fe 2+) form in the duodenum, and to a smaller extent in jejunum Daily recommended allowance o Adult males/postmenopausal females: 8 mg o Menstruating female: 18 mg Iron sources o Heme iron (2 -3 X more absorbable): meat, fish, and poultry o Non-heme iron: vegetables, fruits, dried beans, nuts, grain products, and dietary supplements Gastric acid/ascorbic acid increases non-heme iron absorption whereas phytates (in bran), tannins/polyphenols (in tea), and calcium (in dairy product) form insoluble complexes

Pathophysiology Initial Stage Iron stores are reduced without reducing serum iron levels and can be assessed with serum ferritin measurement Iron stores can be depleted without causing anemia Once iron stores are depleted, there still is adequate iron from daily RBC turnover for Hb synthesis Second Iron deficiency occurs; Hb falls just above the lower limit normal Stage Third Stage Considered as IDA and occurs because of Hb falls to less than normal values

Etiology IDA results from prolonged negative iron balance Mainly due to following factors: 1. 2. 3. 4. Inadequate iron intake Decreased iron absorption Increased iron demand or hematopoiesis Increased iron loss

Common Cause – Age & Sex Females in the reproductive period of life Menstruation Pregnancy Pathological blood loss Deficient diet Adult males and postmenopausal females Pathological blood loss Infants and children Deficient diet Diminished iron stores at birth Etiology

ETIOLOGY The most important cause world-wide is infestation with parasitic worms (hookworms- suck 0. 03 - 0. 2 ml of blood per worm /day ), whipworms, roundworms Dietary insufficiency Malabsorption

Prognosis IDA adversely effects o Cognitive performance, behavior, and physical growth of infants, preschool, and school-aged children o The immune status and morbidity from infections of all age groups o The use of energy sources by muscle and thus the physical capacity and work performance of adolescents and adults of all age groups o Increase perinatal risks for mothers and neonates and overall infant mortality during pregnancy

Diagnosis

Preliminary Findings Chief Complaints Fatigue, lassitude, palpitation, and generalized weakness History Chronic blood loss, deficient diet Clinical Features 1. Palor skin, nailbed, conjunctiva 2. Koilonychia (brittle, spoon shaped nails) 3. Atrophic glossitis (atrophy of tongue papilla; making the tongue smooth and shiny) 4. Pica (compulsive eating of nonfood items) or pagophagia (compulsive eating of ice)

Koilonychia - spoon shaped na


Signs & Symptoms Signs Decreased exercise tolerance Tachycardia Fatigue Pale appearance (most prominent in conjunctiva) Dizziness Decreased mental acuity Irritability Increased intensity of some cardiac valvular murmurs Weakness Palpitations Vertigo Shortness of breath Chest pain

Laboratory Evaluation Complete blood count (CBC), erythrocyte sedimentation rate (ESR), and peripheral blood film (PBF) Serum Iron profile Bone marrow study (if needed) Investigations to determine other causes of IDA (e. g. fecal occult blood test, colonoscopy, urine examination)

Hematological Parameters in IDA Hematologic Indices IDA Hb Low Hematocrit (Hct) Low Mean corpuscular volume (MCV) Low Mean corpuscular hemoglobin (MCH) Low Mean corpuscular hemoglobin concentration (MCHC) Low Red cell distribution width (RDW) High (early)

Iron Profile Lab Exams Serum Fe (50 -100 mcg/d. L) Serum ferritin (>10 -20 mcg/L) Total iron binding capacity (TIBC) (250 -410 mcg/d. L) % Saturation of transferrin (>20%) Comments In IDA 1. 2. 3. 4. It is the concentration bound to transferrin Approximately one-third transferrin bound to iron Levels are decreased by infection and inflammation Best interpreted in conjunction with TIBC Low 1. Ferritin (storage iron) is proportional to total iron stores Best indicator of iron deficiency or overload Infection or inflammation can increase the concentration, independent of iron status Low 2. 3. 1. Indirect measurement of the iron-binding capacity of serum transferrin (protein) 2. Levels don’t fluctuate over hours or days unlike serum iron 1. 2. 3. Ratio of serum iron level to TIBC in percentage Reflects the extent to which iron-binding sites are occupied on transferrin and indicates the availability of iron for erythropoiesis Less sensitive and specific for IDA than ferritin High Low

Algorithm for Diagnosis of IDA

Diagnosis. LABORATORY INVESTIGATIONS Bone marrow aspiration, with the marrow stained for iron Bone marrow is hypercellular, with erythroid hyperplasia Leukocytes and megakaryocytes are normal No stainable iron in marrow reticulum cells

Summary IDA is the most common form of anemia and is usually the result of prolonged negative iron balance in the body Four main factors contributing to IDA include o o Inadequate iron intake Decreased iron absorption Increased iron demand or hematopoiesis Increased iron loss Clinical diagnosis of IDA should include complete patient history and physical exams, followed by laboratory investigations Abnormal laboratory investigations generally include low MCV, serum iron, and ferritin; and high TIBC

Summary Treatment of IDA usually consists of dietary supplementation and administration of oral iron preparations General recommendation for oral iron replacement is 200 mg elemental iron/day, divided into 2 -3 doses to maximize tolerability Parenteral therapy is usually not indicated unless patient is intolerant to oral therapy, having malabsorption, or in the case of CKD Anaphylactic reaction should be considered for all parenteral formulation along with strictly monitoring adverse drug reaction

Summary Decision to manage anemia with blood transfusion is based on the evaluation of the risk and benefit and is only considered when Hb is <70 to 80 g/L Complete therapeutic response requires iron supplementation for up to 2 -6 months, however, symptoms may improve within few days after oral therapy


Self Assessment Questions Q 1: Which of the following is one of the common cause of IDA in young male? A. B. C. D. Deficient diet Menstruation Pathological blood loss None of the above

Self Assessment Questions Q 2: Microcytic hypochromic anemia can be due to the following factor(s): A. B. C. D. Folic Acid Vitamin B 12 Iron deficiency Hemolysis

Self Assessment Questions Q 3: Which of the following statement is false regarding iron in our body? A. B. C. D. It is best absorb in ferrous (Fe 2+) form in the duodenum Heme iron is found in meat, fish, and poultry Gastric acid/ascorbic acid increases non-heme iron absorption Non-heme iron is 2 -3 X more absorbable than heme iron

Self Assessment Questions Q 4: Identify the following laboratory investigations for diagnosing IDA as high/low: Hb MCV Serum iron TIBC Serum ferritin Transferrin saturation Low Low High Low

Self Assessment Questions Q 5: For oral iron products, the following statements are true except: A. B. C. D. Ferrous sulfate tablet contains 65 mg elemental iron Administration of oral iron should be 1 hour before meals or on empty stomach preferably Can cause GI intolerance and discoloration of stools Percent elemental iron of all oral preparations is roughly the same

- Slides: 40